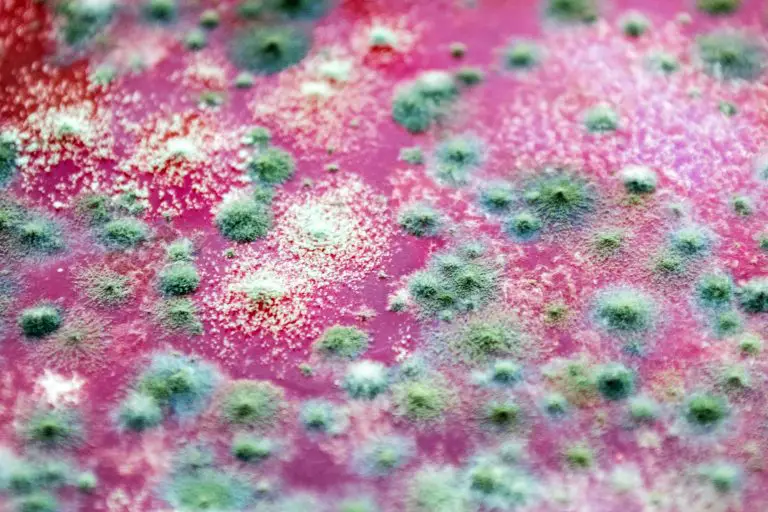
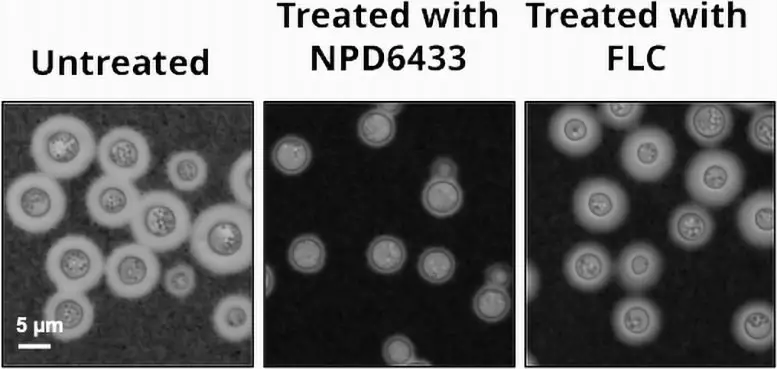

理化学研究所可持续研究科学中心(CSRS)和多伦多大学的研究人员发现了一种防治真菌感染的创新方法。这种方法围绕着阻碍真菌产生脂肪酸(脂肪的主要成分)的能力展开。随着抗真菌药物耐药性的增加,这种以不同方式发挥作用并对多种真菌有效的新方法可能会被证明是特别有益的。这项研究发表在科学杂志《细胞化学生物学》上。
大多数人都知道脚气,这是一种相对良性的健康问题,去药店买点药就能轻松解决。然而,由念珠菌、隐球菌和曲霉菌引起的其他真菌感染却要严重得多。事实上,这些真菌每年造成数百万人死亡。与细菌对抗生素的抗药性不断增强一样,全球范围内对抗真菌药物的抗药性也在不断上升。因此,如果不立即采取干预措施,在可预见的未来,死亡人数很可能还会增加。
真菌(C. neoformans)在三种条件下生长:未处理、使用亚致死剂量的脂肪酸合成酶抑制剂 NPD6433 处理和使用氟康唑处理。经 NPD6433 处理后,真菌的数量和毒力均有所降低。资料来源:理化学研究所
目前,抗真菌药物主要有三种。它们都是通过破坏真菌细胞周围的屏障来发挥作用的。有趣的是,尽管目前所有的治疗方法都以细胞屏障为目标,但它们却具有惊人的物种特异性。这种特异性意味着,对一种真菌有效的药物可能对另一种真菌无效。
研究小组正寻求一种可针对多种真菌的替代策略来对抗有害真菌。他们的方法是首先筛选结构多样的理化学研究所天然产物库(NPDepo),以对抗四种致病性酵母菌。这些酵母菌包括三种念珠菌和一种隐球菌,被世界卫生组织确定为重要的人类病原体。他们的目标是找到一种能影响所有四种菌类的制剂,这表明它能有效对付多种真菌。
筛选过程中发现了几种化合物,它们能使四种真菌中每一种的生长速度至少降低 50%。剔除已知物质后,还剩下三种新的可能性。其中,对人体细胞毒性最小的一种化合物还能抑制曲霉的生长,而曲霉是一种对免疫力低下的人来说普遍存在的致命真菌。理化学研究所 NPDepo 将这种化合物命名为 NPD6433,随后对其进行了进一步分析,以确定其作用机制。
针对近 1000 个不同的基因,科学家们评估了当酵母缺少一个基因拷贝时,NPD6433 对酵母生长的抑制程度。他们发现,只有一个基因(脂肪酸合成酶)的减少提高了酵母对 NPD6433 的易感性。这表明,NPD6433 很可能是通过抑制脂肪酸合成酶来阻止真菌细胞内脂肪酸的合成。随后的实验证明,NPD6433 和另一种脂肪酸合成酶抑制剂 Cerulenin 能够消灭培养物中的多种酵母菌。
在最后的实验中,研究人员在实验室活体模型生物--秀丽隐杆线虫中测试了 NPD6433 的功效,该线虫感染了一种致病性酵母菌,这种酵母菌通过肠道侵入人体后可引起全身感染。之所以选择秀丽隐杆线虫,是因为它的肠道和我们的一样。试验结果表明,用 NPD6433 治疗受感染的蠕虫后,死亡率降低了约 50%。重要的是,对感染了对标准抗真菌药物有抗药性的酵母菌的蠕虫来说,情况也是如此。
"耐药性真菌是一个日益严重的问题,而开发新药的线索为对付这些不断演变的病原体带来了希望,"该研究的主要作者 Yoko Yashiroda 说。"我们的研究表明,以脂肪酸合成为目标是治疗真菌感染的一种很有前景的替代疗法,而且可能不需要为个别物种量身定制解决方案。"